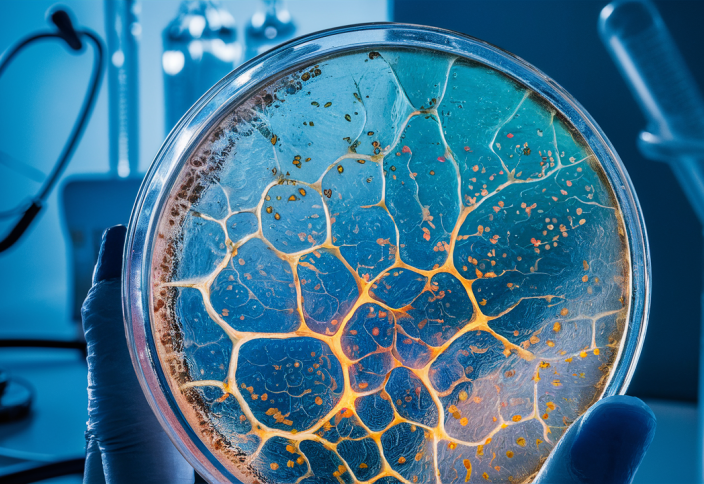
Жарақаттың тез жазылуына ықпал ететін пластыр жасалды

|
Жарақаттың тез жазылуына ықпал ететін пластыр жасалды
|
Ғалымдар зақымдалған тінге (ұлпаға) дәріні қажетті мөлшерде ғана бөлетін молимерлік микромаркер жүйесімен жабдықталған жарақатты таңу материалы жасалды. Бұл жайында islam.kz порталы өз кезегінде ресейлік ғылыми қорға жөн сілтеген pc7ooo.livejournal.com ақпарат көзіне сілтеме жасай отырып мәлім етеді. Жарақат жазылуы үшін немесе қалпына келу процесі тіндегі қышқылдың дәл мөлшерін қажет етеді. Белгілі бір мөлшердегі оттегінің белсенді формасы организмді микробтан қорғап, қалпына келу процесін ынталандырады. Ал сусамыр секілді созылмалы дертке шалдыққан науқастың бойында мұндай қышқыл көп болса, жасушаларға зақым келіп, жараның орны тыртық болып бітеді. Қолданыстағы медициналық таңғыштар мен гидрогелдер қалпына келу процесінің түрлі сатысында қышқылды дәл мөлшерде сақтай алмайды. Осыны ескерген LIFT ғылыми-зерттеу орталығының ғалымдары Сколтехтегі, Сеченов университетіндегі, Саратов медициналық университетінндегң және Чернышевский атындағы мемлекеттік медицина университетіндегі әріптестерімен бірге микрокамералардың реттелетін массивтері бар, биологиялыық тұрғыдан ыдырайтын полимердің негізінде жабын жасады. Оған биологиялық тұрғыдан белсенді заттарды: танил қышқылын (табиғи антиоксидант) немесе натрий перкарбонатын (қан тамырларының өсуін ынталандыру үшін сутегі тотығының көзі) «жүктеуге» болады. Желатин, глицерин және аминокапрон қышқылы негізіндегі гидрогелді пленка пластырдың қан тоқтату қабілетін арттырып, икемділікті және тіндерге берік жабысуын қамтамасыз етеді. Процесс жылдамдығын камералардың полимерлік қабығының құрамы мен қалыңдығын өзгерту арқылы реттеуге болады. Мұндай бірегей әдістің артықшылығы - түрлі заттарды каскадты түрде босату арқылы иерархиялық жүйелерді құруға мүмкіндік береді. Мысалы, бірінші аптада қан тамырлары желісін қалыптастыру үшін тотықтырғыштарды, ал екінші аптада қабынуды төмендету үшін антиоксиданттарды жеткізуге болады. LIFT орталығының ғылыми директоры Глеб Сухоруков технологияны үш жылдан кейін медициналық қолданысқа енгізуді жоспарлап отыр. Алдағы 1-2 жылда статистикалық маңызды терапевтік әсерді растау қажет. Айрықша жүйені жүйке тіндері мен жұлынның күрделі жарақатын емдеуге бейімдемек.













